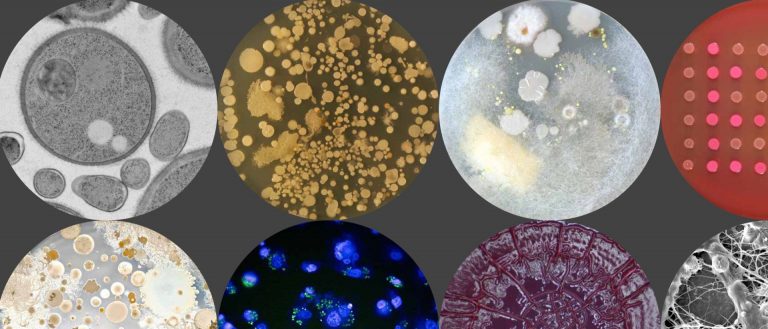

History Scotland webinars
From rioting in 17th century Scotland to Scotland’s first printed book – check out the webinars chaired by Dr Allan Kennedy lecturer in Scottish History. Upcoming sessions include ‘Slaves and Highlanders: Silenced Histories of Scotland and Caribbean’ and ‘Musical life…